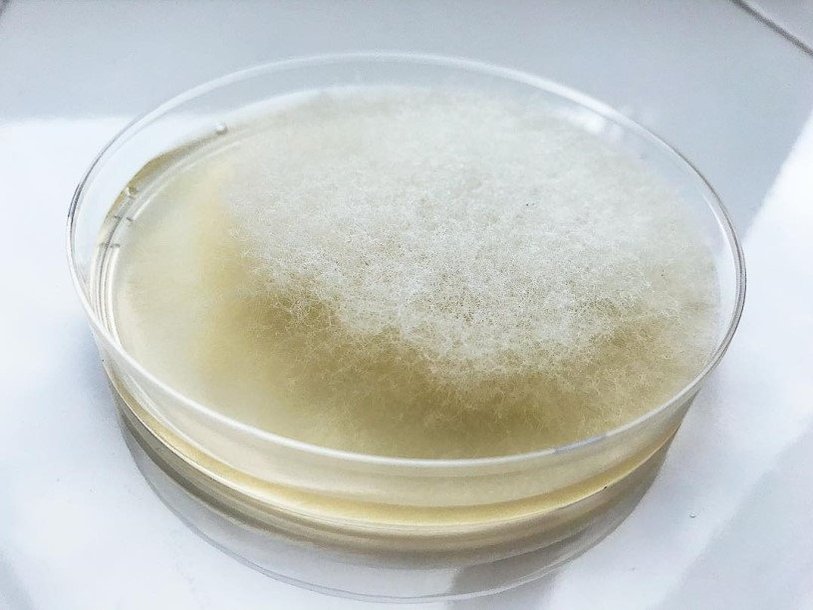

Екатерина Беленко: Промикробы: Цвет настроения — мицелий
Фото: Екатерина Беленко
Фото: Екатерина Беленко Сфера интересов микробиолога — это не только бактерии, но и микроскопические грибы, которые разительно отличаются от бактерий. Но есть и еще кое-кто, давайте же с ним скорее познакомимся. Актиномицеты — это порядок бактерий, имеющих способность к формированию в оптимальных для существования условиях ветвящегося мицелия. То есть это будто нечто среднее между бактериями и грибами, представляете? Мне жуть как нравится устаревшее название актиномицетов — лучистые грибки, гораздо более душевно звучит.
И у грибов мицелий, и у актиномицетов мицелий, но путать их не стоит. Некоторые исследователи, подчеркивая бактериальную природу актиномицетов, даже называют их аналог грибного мицелия тонкими нитями, то есть они придумали отдельный термин. Тонкие нити — действительно тонкие, их диаметр 0,4–1,5 мкм. Актиномицеты имеют кислотоустойчивый тип клеточной стенки, которая окрашивается по Граму как грамположительно, однако по структуре ближе к грамотрицательным. Другими словами, эти малыши во всем стараются быть не как все.
Мицелий у актиномицет еще и имеет свойство дифференцироваться на субстратный (тот, которым они «прирастают» к питательной среде) и воздушный. Воздушный толще, он гидрофобен, содержит больше ДНК и ферментов, на поверхности его клеток имеются различные структуры. еще субстратный и воздушный мицелии обычно имеют разную окраску. Много незабываемых часов провели мы в душных университетских лабораториях, погруженные в древние тома определителя бактерий с желтыми страницами и затхлым ароматом, пытаясь по соотношению двух оттенков разгадать личность, выросшую на чашке Петри. Для этого требовалось определить, бежевый перед тобой, слоновая кость или светло-фисташковый, а чем больше смотришь, тем больше сомневаешься.
Наиболее распространены актиномицеты в почве: в ней обнаруживаются представители почти всех родов актиномицетов. Их экологическая роль заключается чаще всего в разложении сложных устойчивых субстратов; предположительно, они участвуют в синтезе и разложении гуминовых веществ. Это такие гигантские органические молекулы, которые образуются при минерализации органического вещества отмирающих организмов. Гуминовые вещества составляют до 90 % органической массы угля и торфа. Могут выступать симбионтами беспозвоночных и высших растений.
Актиномицеты являются постоянными обитателями кишечника дождевых червей, термитов и многих других беспозвоночных. Разрушая целлюлозу и другие биополимеры, они являются их симбионтами. Представители рода Frankia способны к азотфиксации и образованию клубеньков у небобовых растений (про бобовых и азотфиксацию поподробнее в следующий раз). есть патогенные формы, вызывающие актиномикоз. В организме человека обитают в ротовой полости, в кишечнике, в дыхательных путях, на коже, в зубном налете, в кариозных зубах, на миндалинах. Но лучше пусть живут в почве.
Смотрите также: Екатерина Беленко Промикробы: Броня крепка Екатерина Беленко Промикробы: Повышенная влажность Екатерина Беленко Промикробы: По грибы да по ягоды Екатерина Беленко Промикробы: Грибы большие и маленькие